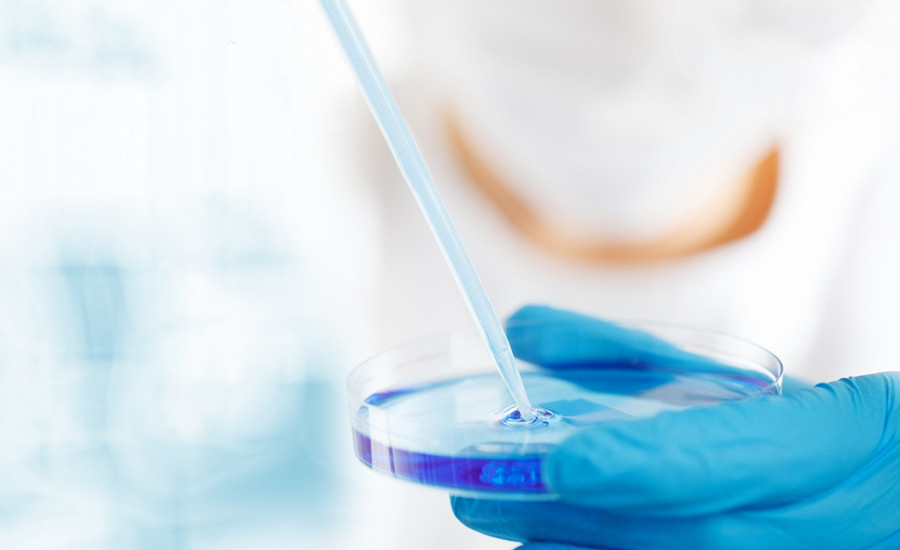
image

Passion (Spain) R&D Center

Passion (Suzhou) R&D Center

Passion (Hunan) R&D Center

Passion (Japan) R&D Center

Joint R&D Center with Institute of Chemistry, Chinese Academy of

Vital Biotechnology (Passion) Joint R&D Center
Chongqing University of Technology (Passion) Joint R&D Center

Polli Aromatic Medicine (Passion) Joint R&D Center